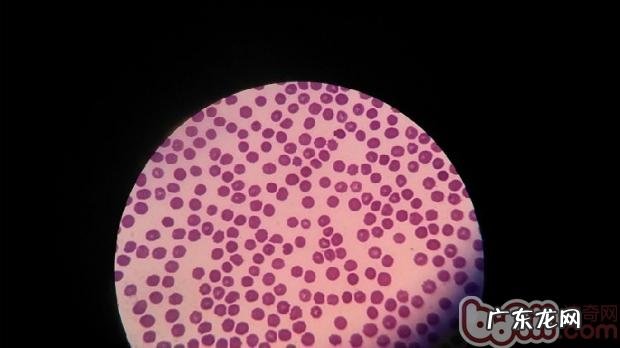
有关小宠物贫血症状及医治

针对养动物的主人家,到医院做检查的情况下,医师很有可能要说这只狗或猫存有缺铁性贫血 。可是大部分状况下都不容易很高度重视这个问题 。这一一方面是由于许多 小动物缺铁性贫血较为普遍,另一个缘故可能是医师沒有做详尽的查验 。实际上缺铁性贫血也是分许多 状况的,大家必须综合性的去对待这个问题 。

文章插图
生病小狗
说白了缺铁性贫血,指的是循环系统血夜中的血细胞数或血红蛋白浓度数小于标准值时的情况 。缺铁性贫血并并不是一种单一病症,大量的是一种或几类病症的症型主要表现 。造成 贫血的原因许多 ,归纳起來能够分成二种:血细胞形成不够或耗损过多 。

文章插图
生病小狗
(口腔粘膜惨白,缺铁性贫血的典型症状)
临床医学上看的数最多的应该是小狗狗的营养性贫血,这一大多数全是刚养动物的主人家在沒有工作经验的状况下导致的,因为喂养的造化弄人当不科学所造成 的 。解决方案非常简单,小狗狗必须少食多餐及其高蛋白食物的食材 。通俗化的说便是让它"吃好"就可以了 。

文章插图
检验数据信息
(血液检查单里RBC、HGB、HCT均小于标准值,典型性的缺铁性贫血查验結果)
血细胞形成降低,也叫再造再障性贫血 。造成 这类贫血的原因许多 ,如骨髓造血功能降低或铁的运用阻碍造成 的血红蛋白浓度形成阻碍(严苛实际意义上讲这类归属于营养性贫血的范围) 。在再造再障性贫血的血常规检查中由此可见RBC减少,而血涂片中却末见网织红细胞 。

文章插图
血细胞
(血涂片中血细胞中间恬淡区扩张,多见缺铁性或渗出性缺铁性贫血的标示)
血细胞耗损过多分成二种状况,失血过多和溶血症 。
失血过多,又分成亚急性失血过多和漫性失血过多 。分辨根据最先能够依据小动物的情况,亚急性失血过多常见于创伤,手术或是一些凝血功能功能欠佳状况 。可是很令人费解的是这个时候的血液检查指标值却很有可能显示信息一切正常 。由于亚急性失血过多的第一个反映便是肝脏的收拢,促使血细胞进到到循环系统池 。这促使许多 指标值如HCT待会升高,随后又因为循环系统血的浓度值上升,人体内的水份进到到毛细血管内淡化血细胞促使HCT又降至一切正常范畴,接下去的三天内,人体便会有一个代偿性的回复 。在这类状况下的血涂片可看到血细胞大小不一,另外因为失血过多造成 Fe的遗失,会见到许多 低色素性血细胞(又叫小血细胞) 。

文章插图
生病小狗
(细微因拉血造成 的失血过多,细微的患犬现病史中缺铁性贫血比较严重)
溶血性贫血则能够分成血细胞本身缘故的溶血性贫血,及其血细胞所处自然环境造成 的溶血性贫血 。前面一种大多数是遗传先天的,后则有先天也是有后天 。看的比较多的缘故有药源性的溶血症(阿斯匹林),微生物原性的溶血症(巴贝斯虫),中毒了(铅中毒症状),及其一些缘故造成 的血细胞被氧化(吃完圆葱) 。这个时候血涂片具备很重要的确诊实际意义 。如见到巴贝斯虫,见到海恩次小体,球型红细胞增多等 。
特别声明:本站内容均来自网友提供或互联网,仅供参考,请勿用于商业和其他非法用途。如果侵犯了您的权益请与我们联系,我们将在24小时内删除。
